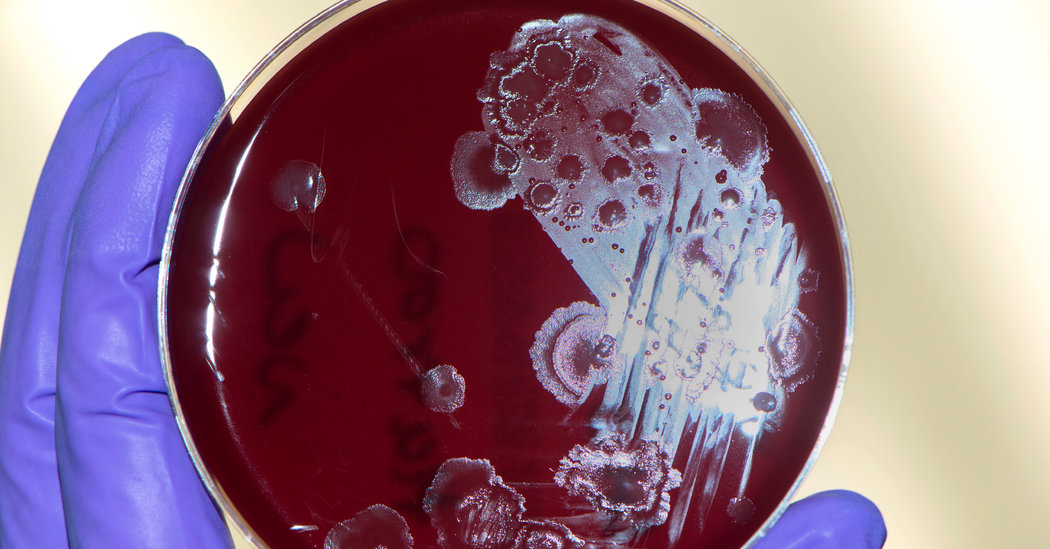

Buy Clotilde's latest book, The French Market Cookbook! In addition to planning my menus, I have been doing more and more batch cooking these past few months. The idea of batch cooking is to block out time one day of the week to prep or cook a bunch of ingredients in advance, which you can draw...

Recent Comments